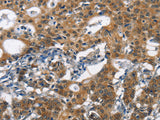
DCC Polyclonal Antibody Store at -20°C

DCC Polyclonal Antibody Store at -20°C
SKU: E-AB-15932-200
DCC Polyclonal Antibody Store at -20°C
| SKU # | E-AB-15932 |
| Reactivity | Human, Mouse, Rat |
| Host | Rabbit |
| Applications | IHC |
Product Details
| Isotype | IgG |
| Host | Rabbit |
| Reactivity | Human, Mouse, Rat |
| Applications | IHC |
| Clonality | Polyclonal |
| Immunogen | Synthetic peptide of human DCC |
| Abbre | DCC |
| Synonyms | CRC 18, CRC18, CRCR 1, CRCR1, Colorectal cancer related chromosome sequence 18, Colorectal cancer suppressor, DCC, Deleted in colorectal cancer protein, Deleted in colorectal carcinoma, Immunoglobulin superfamily DCC subclass member 1, Netrin receptor DCC, Tumor |
| Swissprot | |
| Cellular Localization | Membrane. |
| Concentration | 0.7 mg/mL |
| Buffer | Phosphate buffered solution, pH 7.4, containing 0.05% stabilizer and 50% glycerol. |
| Purification Method | Affinity purification |
| Research Areas | Cancer, Cell Biology, Epigenetics and Nuclear Signaling, Neuroscience |
| Conjugation | Unconjugated |
| Storage | Store at -20°C Valid for 12 months. Avoid freeze / thaw cycles. |
| Shipping | The product is shipped with ice pack,upon receipt,store it immediately at the temperature recommended. |
Related Reagents
| Applications | Recommended Dilution |
| IHC | 1:50-1:200 |
Background
This gene encodes a netrin 1 receptor. The transmembrane protein is a member of the immunoglobulin superfamily of cell adhesion molecules, and mediates axon guidance of neuronal growth cones towards sources of netrin 1 ligand. The cytoplasmic tail interacts with the tyrosine kinases Src and focal adhesion kinase (FAK, also known as PTK2) to mediate axon attraction. The protein partially localizes to lipid rafts, and induces apoptosis in the absence of ligand. The protein functions as a tumor suppressor, and is frequently mutated or downregulated in colorectal cancer and esophageal carcinoma.